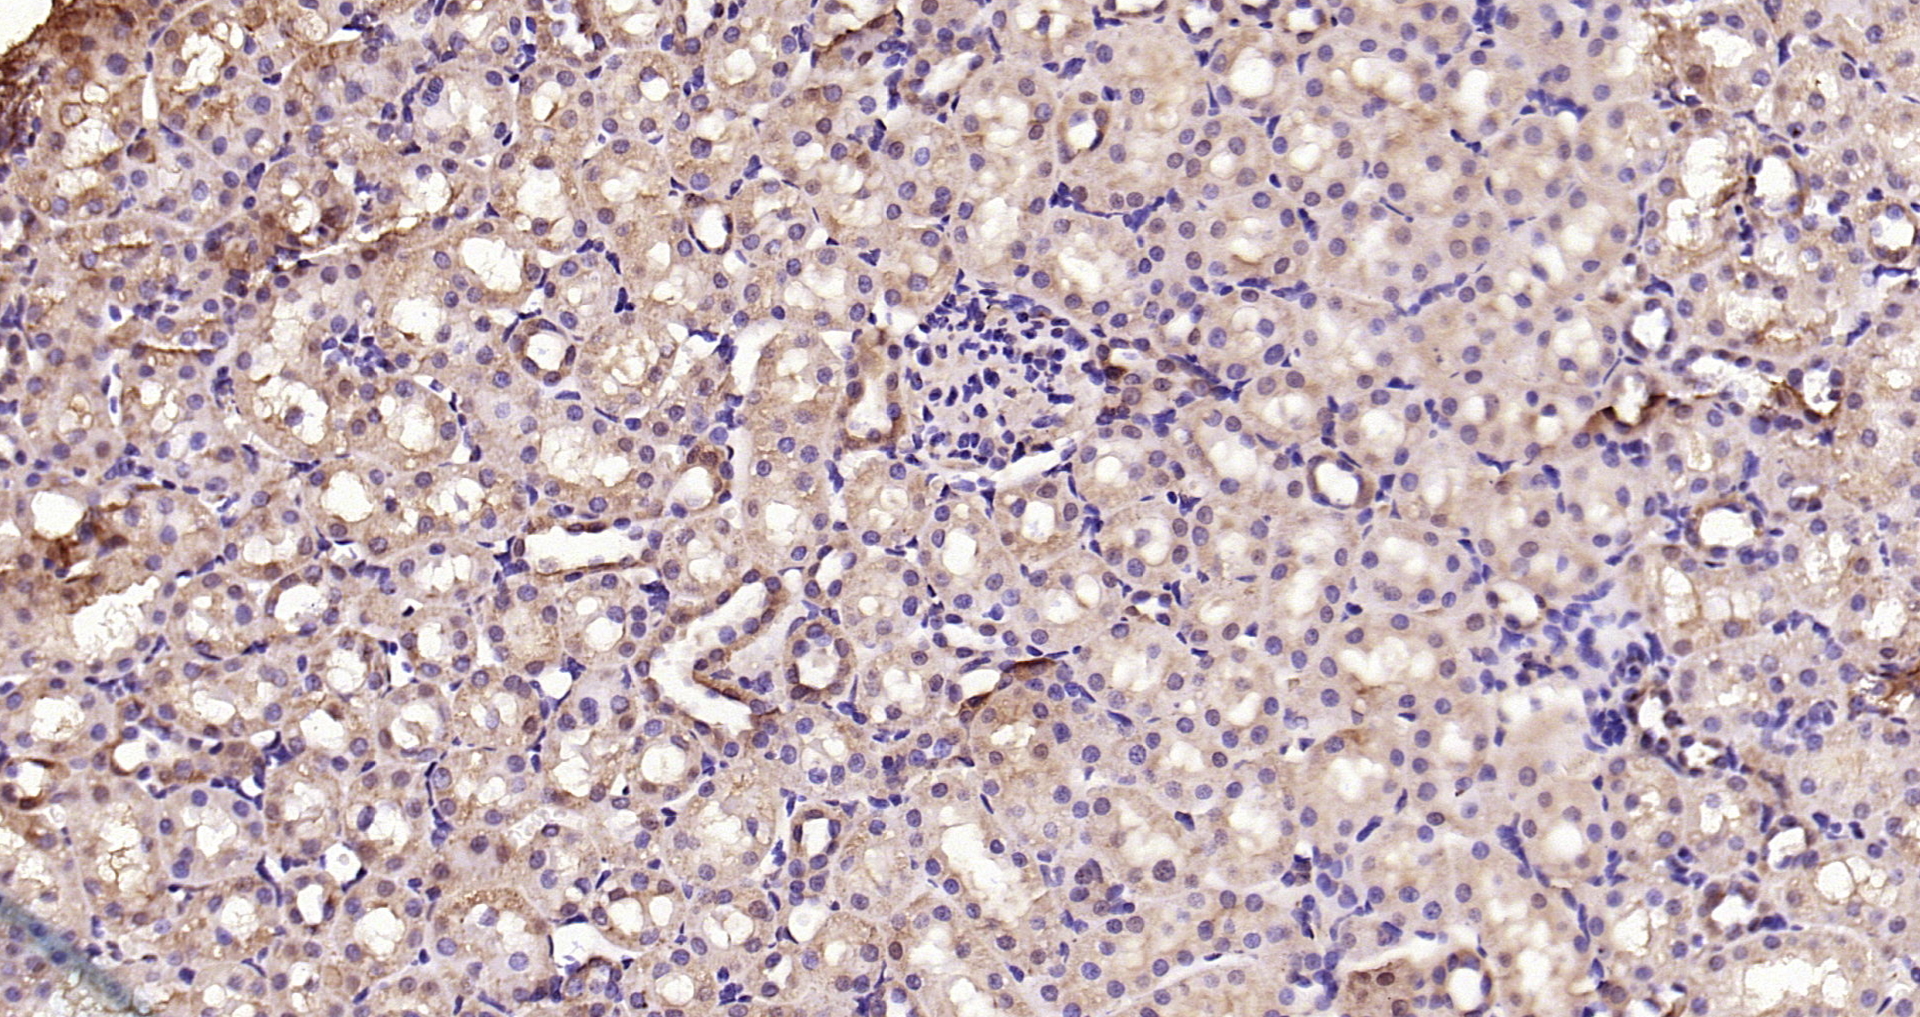

HUVEC cells(black) were fixed with 4% PFA for 10min at room temperature,permeabilized with 90% ice-cold methanol for 20 min at -20℃, and incubated in 5% BSA blocking buffer for 30 min at room temperature. Cells were then stained with Smad3 (Ser423 + Ser425) Polyclonal Antibody(bs-3425R)at 1:50 dilution in blocking buffer and incubated for 30 min at room temperature, washed twice with 2% BSA in PBS, followed by secondary antibody(blue) incubation for 40 min at room temperature. Acquisitions of 20,000 events were performed. Cells stained with primary antibody (green), and isotype control (orange).
Phospho-Smad3 (Ser423 + Ser425) Polyclonal Antibody
BS-3425R
ApplicationsFlow Cytometry, ImmunoFluorescence, Western Blot, ELISA, ImmunoCytoChemistry, ImmunoHistoChemistry, ImmunoHistoChemistry Frozen, ImmunoHistoChemistry Paraffin
Product group Antibodies
TargetSMAD3
Overview
- SupplierBioss Antibodies
- Product NameSmad3 (Ser423 + Ser425) Antibody
- Delivery Days Customer16
- ApplicationsFlow Cytometry, ImmunoFluorescence, Western Blot, ELISA, ImmunoCytoChemistry, ImmunoHistoChemistry, ImmunoHistoChemistry Frozen, ImmunoHistoChemistry Paraffin
- Applications SupplierWB(1:300-5000), ELISA(1:500-1000), FCM(1:20-100), IHC-P(1:200-400), IHC-F(1:100-500), IF(IHC-P)(1:50-200), IF(IHC-F)(1:50-200), IF(ICC)(1:50-200)
- CertificationResearch Use Only
- ClonalityPolyclonal
- Concentration1 ug/ul
- ConjugateUnconjugated
- Gene ID4088
- Target nameSMAD3
- Target descriptionSMAD family member 3
- Target synonymshMAD-3; hSMAD3; HSPC193; HsT17436; JV15-2; LDS1C; LDS3; MAD homolog 3; mad homolog JV15-2; mad protein homolog; MAD, mothers against decapentaplegic homolog 3; mad3; MADH3; mothers against decapentaplegic homolog 3; mothers against DPP homolog 3; SMA- and MAD-related protein 3; SMAD, mothers against DPP homolog 3
- HostRabbit
- IsotypeIgG
- Protein IDP84022
- Protein NameMothers against decapentaplegic homolog 3
- Storage Instruction-20°C
- UNSPSC12352203
References
- Smad signaling coincides with epithelial-mesenchymal transition in a rat model of intrauterine adhesion. Guo LP et al., 2019, Am J Transl ResRead more
- Knockdown of microRNA-17-5p Enhances the Neuroprotective Effect of Act A/Smads Signal Loop After Ischemic Injury. Wang JQ et al., 2019 Aug, Neurochem ResRead more
- Smad Anchor for Receptor Activation and Phospho-Smad3 Were Upregulated in Patients with Temporal Lobe Epilepsy. Zhang W et al., 2019 May, J Mol NeurosciRead more
- Angelica polysaccharides inhibit the growth and promote the apoptosis of U251 glioma cells in vitro and in vivo. Zhang WF et al., 2017 Sep 15, PhytomedicineRead more
- Telmisartan improves vascular remodeling through ameliorating prooxidant and profibrotic mechanisms in hypertension via the involvement of transforming growth factor-beta1. Shang P et al., 2017 Oct, Mol Med RepRead more
- BAMBI promotes porcine granulosa cell steroidogenesis involving TGF-beta signaling. Bai L et al., 2017 Sep 15, TheriogenologyRead more
- Acetyl-11-Keto-beta-Boswellic Acid Attenuates Prooxidant and Profibrotic Mechanisms Involving Transforming Growth Factor-beta1, and Improves Vascular Remodeling in Spontaneously Hypertensive Rats. Shang P et al., 2016 Dec 23, Sci RepRead more
- Hydroxysafflor Yellow A Ameliorates Renal Fibrosis by Suppressing TGF-beta1-Induced Epithelial-to-Mesenchymal Transition. Hu N et al., 2016, PLoS OneRead more
- Salidroside protects against bleomycin-induced pulmonary fibrosis: activation of Nrf2-antioxidant signaling, and inhibition of NF-kappaB and TGF-beta1/Smad-2/-3 pathways. Tang H et al., 2016 Mar, Cell Stress ChaperonesRead more
- Breast cancer cells promote a notch-dependent mesenchymal phenotype in endothelial cells participating to a pro-tumoral niche. Ghiabi P et al., 2015 Jan 27, J Transl MedRead more